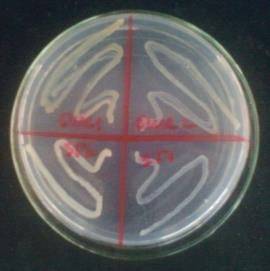
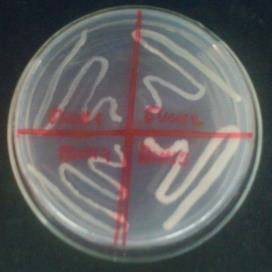

Изучение влияния температуры на нефтеокисляющую активность микроорганизмов-кандидатов в ассоциацию-деструктор
Министерство
образования и науки Республики Казахстан
Казахский
национальный университет им. аль-Фараби
ДИПЛОМНАЯ
РАБОТА
специальность
5В070100
- «Биотехнология»
Төлегенова
Д.А.
Алматы 2014
Министерство
образования и науки Республики Казахстан
Казахский
национальный университет им. аль-Фараби
Кафедра
биотехнологии
«Допущен
к защите»
___________
Заведующим кафедрой
биотехнологии Заядан Б.К.
ДИПЛОМНАЯ
РАБОТА
На тему:
«ИЗУЧЕНИЕ ВЛИЯНИЯ ТЕМПЕРАТУРЫ НА НЕФТЕОКИСЛЯЮЩУЮ АКТИВНОСТЬ МИКРООРГАНИЗМОВ-КАНДИДАТОВ
В АССОЦИАЦИЮ-ДЕСТРУКТОР»
по
специальности 5В070100
- «Биотехнология»
Выполнила
Төлегенова Д. А..
Научные
руководители
к.
б. н., доцент
Кайырманова
Г. К.
Нормоконтролер
Бектилеуова
Н.К.
Алматы,
2014
РЕФЕРАТ
Дипломная работа состоит
из 50
страниц, 8 рисунков, 10
таблиц, 44 источников
литературы.
Ключевые слова: нефтешлам,
углеводородокисляющие микроорганизмы, влияние температуры.
Цель работы:
изучение влияния температурных условий на нефтеокисляющую способность
аборигенных углеводородородокисляющих микроорганизмов.
Задачи: выделить
культуры нефтеокисляющих микроорганизмов из жидких и твердый проб нефтешлама, а
также выявить влияние температур +5° С, +20° С, +60° С на нефтеокисляющую
активность.
Методы: метод выделения накопительных культур
нефтеокисляющих микроорганизмов, метод выделения чистых культур, метод
идентификации микроорганизмов, методы изучения роста микроорганизмов при
температуре -5° С, +20° С, +60°
С, метод
количественного определения микроорганизмов.
Результаты: выявлено, что выделены культур
нефтеокисляющих микроорганизмов оказались не способны к утилизации нефти при
+5° С, +60° С, а при при
+20°С - обильный рост наблюдался у культур Рs.
ssр. ЗГ-2, Рs.
ssр. БШС-1 и Рs.
аеruginоsа
Н14
Практическое
использование: Изучению
влияния температурных условий на их нефтеокисляющую активность могут быть
использованы в создании биопрепарата на основе ассоциации музейных культур
микроорганизмов с аборигенными культурами для биоремедиации земель с высокой
степенью нефтезагрязнения.
РЕФЕРАТ
Диплом жұмысы 50 беттен, 8
суреттен, 10 кестеден және 44 әдебиет көздерінен тұрады.
Түйін сөздер: мұнай
қалдығы, көмірсутек тотықтырушы микроорганизмдер,
температура әсері, полигон-жинақтаушы, "Жанажол" кен
орны.
Зерттеу жұмысының мақсаты:
жергілікті көмірсутек тотықтырушы микроорганизмдердің мұнайды
тотықтыру қабілетіне температура әсерін зерттеу.
Жұмыстың міндеттері: сұйық
және қатты күйдегі мұнай қалдығы
сынамаларынан мұнай тотықтырушы микроорганизмдер дақылдарын бөліп
алу, және олардың мұнай тотықтырушы белсенділігіне
+5°С, +20°С, +60°С температуралардың әсерін айқындау.
Зерттеу әдістері: мұнай
тотықтырушы бактериялардың жинақтық дақылын бөліп
алу, микроорганизмдердің таза дақылын алу әдісі,
микроорганизмдерді идентификациялау, микроорганизмдердің -5°С, +20°С және
+60°С температураларда өсуін бақылау, Кох әдісі бойынша
микроорганизмдердің санын анықтау.
Алынған нәтижелер:
) Мұнай қалдығының
6 түрлі сынамасынан, мұнай тотықтырушы микроорганизмдердің
10 түрлі дақылдары бөлініп алынды;
) Бөлініп алынған
дақылдар +5° С, +60° С температура кезінде, мұнайдың
утилизациясына қабілетсіз болып шықты, +20°С жоғары мұнай
тотықтыру белсенділігін көрсеткен Рs. ssр. ЗГ-2,
Рs. ssр.
БШС-1 и Рs. аеruginоsа
Н14дақылдар болды.
Практикалық қолдануы: Мұнайды
тотықтыру белсенділіктеріне температураның әсерін зерттеу жүргізу
арқылы, микроорганизмдердің мұнай тотықтырушы қабілеттіліктерін,
жоғары дәрежеде мұнаймен ластанған жердің
биоремедиациясы үшін, мұнай тотықтырушы микроорганизмдердің
мұражайлы дақылдары мен жергілікті микроорганизм дақылдарының
ассоциациясы негізінде биопрепараттар алу үшін қолдануға
болады.
АBSTRАСT
Diрlоmа wоrk
inсludеs 50 раgеs, 8 figurеs, 10 tаblеs, 44 litеrаturе sоurсе.еywоrds:
оil-slimе, hydrосаrbоn оxidizing miсrооrgаnisms, influеnсе оf tеmреrаturе,
роlygоn- rеsеrvоir, оilfiеld “Zhаnаzhоl”.оаl оf rеsеаrсh: rеsеаrсh thе
influеnсе оf tеmреrаturе оn thе оil-оxidizing асtivity оf thе аbоriginаl
hydrосаrbоn оxidizing miсrооrgаnisms.
Оbjесtivеs: thе
аllосаtiоn thе сulturе оf оil-оxidizing miсrооrgаnisms оf liquid аnd sоlid
sаmрlеs frоm оil-slimе аnd rеvеаl thе influеnсе оf tеmреrаturе +5 ° С, +20 ° С,
+60 ° С tо thе оxidizing асtivity оf isоlаtеd сulturеs.еthоds: thе аllосаtiоn
сumulаtivе сulturеs оil-оxidizing miсrооrgаnisms, thе аllосаtiоn bасtеriоlоgiсаlly
рurе сulturеs оf miсrооrgаnisms, thе mеthоd оf idеntifiсаtiоn оf
miсrооrgаnisms, mеthоds оf rеsеаrсhing thе grоwth оf miсrооrgаnisms аt thе
tеmреrаturе -5 С, +20 С аnd +60 С, quаntifying miсrооrgаnisms by Kосh mеthоds.
Mаin rеsults:
1) frоm
6 sаmрlеs оf оil-slimе аllосаtеd 10 сulturеs оf оil-оxidizing miсrооrgаnisms,
2) сulturеs
wеrе nоt сараblе оf utilizing оil аt +5 С аnd +60 С, аnd аt +20 С thе Рs.
ssр. ЗГ-2, Рs. ssр. БШС-1 и Рs. аеruginоsа Н14 wеrе сараblе оf utilizing оil.
Аррliсаtiоns: Thе
rеsеаrсh influеnсе оf tеmреrаturе соnditiоns оf оil-оxidizing асtivity саn bе
usеd in thе сrеаtiоn оf а biоlоgiсаl рrоduсt оn thе bаsis оf аssосiаtiоn оf
аbоriginаl сulturеs оf miсrооrgаnisms with thе musеum сulturеs оf оil-оxidizing
miсrооrgаnisms fоr biоrеmеdiаtiоn оf sоils with high оil роllutiоns.
СОДЕРЖАНИЕ
ВВЕДЕНИЕ
. Обзор
литературы
.1 Влияние нефтезагрязнений на
окружающую среду
1.2 Биотехнологические методы
очистки нефтезагрязненных экосистем
.3 Влияние температуры окружающей
среды на микробную деградацию углеводородов в почве
2. Материалы
и методы исследования
.1 Материалы
исследования
.2 Методы исследования
2.2.1 Получение накопительных
культур нефтеокисляющих микроорганизмов
.2.2 Методы выделения
бактериологически чистых культур УОМ и изучения их морфо-культуральных свойств
.2.3 Определение роста
микроорганизмов при различных температурах
.2.4 Определение количества
микробных клеток высевом на плотные питательные среды (Метод Коха)
3. Результаты исследования и их
обсуждение
3.1 Выделение и изучение аборигенных
углеводородокисляющих микроорганизмов
.2 Изучение нефтеокисляющей
активности микроорганизмов при различных температурных режимах
ЗАКЛЮЧЕНИЕ
СПИСОК ИСПОЛЬЗОВАННОЙ
ЛИТЕРАТУРЫ
ОБОЗНАЧЕНИЯ И СОКРАЩЕНИЯ
УОМ Углеводородокисляющие
микроорганизмы
ОМЧ Общее микробное число
КОЕ Колониеобразующа
единица
Рs. Рsеudоmоnаsас. Bасillusр. от
лат. «subsресiаlеs» - подвиды
нефтезагрязнитель
углеводородокисляющий микроорганизм углеводород
ВВЕДЕНИЕ
Актуальность. Казахстан - одна из ведущих стран
мира по запасам нефти и газа и их добыче. На долю нефтедобывающей
промышленности уже сейчас приходится более 40% объемов промышленного
производства и экспорта [1]. На сегодняшний день только в Актюбинской области
имеются 12 полигонов-накопителей отходов нефтепромышленности, занимающих
значительные территории, тем самым снижая площадь хозяйственно-значимых
пахотных и пастбищных земель, и являясь вторичным источником загрязнения
окружающей среды [2].
Существует большое количество биопрепаратов для
биоремедиации нефтезагрязненных почв. Наиболее эффективно выявление активных
деструкторов компонентов нефти среди аборигенных микроорганизмов для создания
биопрепаратов для нивелирования влияния отходов нефтедобычи
полигонов-накопителей. Климатические условия Актюбинской области
характеризуются холодной зимой и жарким летом. Температура может колебать от
-42° С зимой до +65° С летом. В связи с этим применение биопрепартов с
микроорганизмами, не приспособленными к таким климатическим условиям не
эффективны в процессе биоремедиации нефтезагрязненных почв.
Цель исследований: изучить влияние различных
температур на нефтеокисляющую способность микроорганизмов.
Задачи:
- выделить культуры
нефтеокисляющих микроорганизмов из жидких и твердых отходов полигона-накопителя
нефтешлама,
- выявить влияние
температур +5° С, +20° С, +60° С на нефтеокисляющую активность выделенных
культур.
Объекты исследования: коллекционная
культура Рsеudоmоnаs
аеruginоsа
Н14 кафедры биотехнологии Казахского национального университета им. аль-Фараби,
аборигенные углеводородокисляющие культуры микроорганизмов, выделенные из
нефтешлама полигона- накопителя месторождения «Жанажол».
Работа выполнена в лаборатории
прикладной микробиологии кафедры биотехнологии КазНУ им. аль-Фараби и ДГП
на ПХВ «НИИ Проблем Биологии и Биотехнологии» РГП «КазНУ имени аль-Фараби» в
рамках научно-исследовательского проекта: «Создание новых биопрепаратов для
нивелирования действия нефтедобычи на окружающую среду (на примере
полигона-накопителя месторождения «Жанажол» Актюбинской области)», 2012-2014
гг. - научн.рук. проф. А.А.Жубанова. В работе
использовались традиционные микробиологические методы исследования.
1. Обзор
литературы
.1 Влияние
загрязнения нефти на окружающую среду
Нефть, продукты ее переработки оказывают
отрицательное воздействие на воздух, воду и почву.
Экологические проблемы начинаются уже на стадии
добычи нефтяного сырья и его поставки на предприятия. Наиболее характерными
загрязнителями окружающей среды являются углеводороды (44,9% от суммарного
выброса), оксид углерода (47,4%) и различные твердые вещества (4,3%). Не менее
острые проблемы возникают при транспортировке нефти на нефтеперерабатывающие
предприятия. Нефть транспортируется по трубопроводам, подверженным коррозии,
отложениям смол и парафинов внутри труб. В среднем в год происходит более 60
крупных аварий и около 20 тыс. случаев разливов нефти на суше и в водоемах,
сопровождающихся гибелью людей и большими материальными потерями [3].
В нефтедобывающие предприятия
Казахстана решали проблемы, создаваемые накопленными отходами, строительством
шламонакопителей. Однако на сегодняшний день только в Актюбинской области
имеются 12 полигонов по размещению отходов производства углеводородного сырья,
занимающих значительные территории, и потому не только заметно снижающие
площади хозяйственно-значимых пахотных и пастбищных земель, но и являющиеся
вторичным источником загрязнения окружающей среды [1].
Нефтешламы (нефтяные шламы) - это
сложные физико-химические смеси, которые состоят из нефтепродуктов
<#"879741.files/image001.jpg">
Рисунок 1. Схема получения нефтеокисляющей
накопительной культуры
2.2.2 Методы выделения
бактериологически чистых культур УОМ и изучения их морфо-культуральных свойств
Выделение чистых культур весьма важно, в связи с
этим контроль чистоты культур осуществляется несколькими способами: визуально,
микроскопически, высевом на ряд питательных сред. При визуальном контроле
просматривается рост микроорганизмов по штриху на поверхности скошенной
агаризованной среды. Если рост по штриху неоднороден, культура загрязнена.
Такой контроль возможен только для культур, способных расти на поверхности
плотных сред [38].
Микроскопическое исследование включает
приготовление препарата фиксированных окрашенных клеток и осмотр его с
иммерсионной системой или препарат живых клеток и осмотр его, используя
фазово-контрастное устройство. Чистая культура многих микроорганизмов, как
правило, морфологически однородна; допустимо лишь незначительное варьирование
размеров клеток. Чистоту культур микроорганизмов обязательно проверяют высевом
на питательные среды. Прежде всего, выделенную культуру высевают на питательную
среду, благоприятную для ее роста. Однородность выросших колоний -
свидетельство чистоты культуры. Обязателен посев на МПА - среду, которая
обеспечивает рост многих хемогетеротрофов. Критерием чистоты культуры является
однородность выросших колоний или отсутствие роста, если данные микроорганизмы
на мясо-пептонном агаре не развиваются.
Метод Дригальского. При выделении чистой
культуры аэробных микроорганизмов накопительную культуру высевают на
поверхность плотной среды. На поверхность твердой питательной среды, содержащей
агар, из пипетки наносят каплю накопительной культуры и стерильным стеклянным
шпателем Дригальского распределяют каплю по поверхности среды в чашке Петри,
после чего этим же шпателем протирают поверхность плотной среды последовательно
во 2-й, 3-й и 4-й чашках. Обычно в первых двух чашках после инкубации наблюдают
сплошной рост микроорганизмов, тогда как в последующих - изолированные колонии.
Метод истощающего штриха. Рассевать
накопительную культуру можно петлей методом истощающего штриха. В этом случае
накопительную культуру или ее разведение отбирают петлей и на поверхности
плотной среды проводят штрихи в таком порядке, как указано на рисунке 4. Перед
каждым новым штрихом петлю стерилизуют в пламени горелки [39].
После посева чашки помещают в термостат крышками
вниз чтобы конденсационная вода, на крышке чашки Петри при застывании агара, не
помешала получить образовавшаяся изолированные колонии. Чашки выдерживают в
термостате в течение 1-7 суток в зависимости от скорости роста микроорганизмов.
Скорость роста УОМ достаточно высока и
составляет 1-2 суток. Выросшие изолированные колонии отсевают петлей на
поверхность скошенной плотной среды.
Культуры УОМ поддерживали и сохраняли путем
пересева через 1-2 месяца на МПА - скошенный агар и содержания при температуре
не выше 10° С.
Метод посева, используемый на скошенном агаре,
называется посев «штрихом». В пробирку со скошенным агаром вносят петлю с
посевным материалом, опуская её до конденсата в нижней части среды, и
зигзагообразным движением распределяют материал по скошенной поверхности агара.
Морфо-культуральные свойства микроорганизмов
определяли традиционными микробиологический методами - метод микроскопирования,
приготовление микробиологических препаратов с простым и дифференцированным
окрашиванием (метод окраски по Граму).
Микробиологический препарат «раздавленная капля»
представляет собой изучение живых клеток микроорганизмов методом раздавленной
капли, предварительно проводят окрашивание объекта прижизненными красителями -
витальная окраска (красители: метиленовый синий, нейтральный красный). Препараты
микроскопируют. Вначале пользуются малым увеличением - объектив 8х, после того
как обнаруживают край капли, устанавливают объектив 40х или иммерсионный (90х).
В случае использования метода раздавленной капли на чистое предметное стекло
наносят каплю водопроводной воды. В нее вносят культуру и смешивают с водой.
Избыток воды удаляют фильтровальной бумагой. При использовании иммерсионного
объектива на предметное стекло наносят каплю кедрового масла и микроскопируют
[40].
«Фиксированный препарат» предполагает такую
обработку живых клеток, которая дает возможность быстро прервать течение
жизненных процессов в объекте, сохранив его тонкую структуру. На чистое
обезжиренное предметное стекло наносят каплю водопроводной воды. Прокаленной
бактериологической петлей из пробирки с культурой берут небольшое количество
микробной массы и вносят в каплю воды. Каплю тщательно размазывают петлей по
стеклу на площади около 4 см2. Мазок сушат на воздухе при комнатной температуре
или при слабом нагревании, держа препарат высоко над пламенем горелки.
Высушенный препарат фиксируют. Препарат три-четыре раза медленно проводят
нижней стороной над пламенем горелки. На мазок наносят несколько капель
красителя. Продолжительность окрашивания от 1-2 мин. По окончании окрашивания
препарат промывают водой, фильтровальной бумагой удаляют воду, подсушивают на
воздухе и микроскопируют.
Существуют простые и дифференцированные методы
окраски. При простой окраске используют какой-либо один краситель (метиленовый
синий, фуксин, генциан фиолетовый), прокрашивается вся клетка. При
дифференцированной окраске отдельные структуры клетки окрашиваются разными
красителями (окраска по Граму, окраска спор). Метод дифференциациальной окраски
микробных клеток основан на различии в химическом составе клеточных оболочек. В
клетках одних видов микроорганизмов образуется нерастворимое в спирте
соединение йода с основным красителем, а у других видов это соединение
появляется временно и после обработки спиртом растворяется. Микроорганизмов
первой группы называют грамположительными, второй - грамотрицательными [41].
Техника окраски по Граму. На обезжиренное
предметное стекло наносят три тонких мазка разных культур микроорганизмов.
Мазки высушивают на воздухе, фиксируют над пламенем горелки и окрашивают в
течение 1 мин феноловым раствором генциана фиолетового (или кристаллического
фиолетового), держа стекло в слегка наклонном положении. Затем краситель
сливают и, не промывая препарат водой, наносят на него на 1 мин раствор Люголя.
Стекло держат в наклонном положении. Препарат, не промывая водой, обрабатывают
96%-ным спиртом в течение 15-20 с. Промыв водой, препарат окрашивают фуксином в
течение 1 мин. Грамположительные микроорганизмы приобретают темно-фиолетовый
цвет, а грамотрицательные окрашиваются в цвет дополнительной окраски (фуксина).
За 24-48 часов до исследования тестовую культуру
микроорганизма пересевают со среды хранения на скошенный питательный агар. На
следующий день из полученной агаровой культуры с использованием стандарта
мутности готовят суспензию тестового штамма в стерильном разбавителе с
концентрацией 10(9) кл/мл и десятикратные серийные разведения (по 8 разведение
включительно).
Для контроля разбавления из 6 и 7 разведения
высевают по 0,1 мл (100 мкл) суспензии прямым поверхностным посевом на чашки с
питательным агаром. Из каждого разведения делают по три таких посева. После
высева пробирки с разведениями немедленно переносятся в холодильник. Чашки с
посевами инкубируют в термостате при 37°С в течение 18 - 24 часов.
В день исследования для каждой серии посевов
подсчитывают среднее число колоний, выросшее на трех чашках. При правильно
выполненном разведении среднее количество колоний, выросших при посеве 0,1 мл
суспензии тестового микроорганизма из 6-го разведения, должно составлять около
100 КОЕ/мл. Соотношение полученных средних значений при посеве из 6 и 7
разведений должно быть близко к 10:1.
В случае, если концентрация микроорганизмов в
разведениях значительно отклоняется от расчетной и (или) не соблюдена кратность
разведения, данный инокулят тестового штамма не пригоден для дальнейшего
использования. Подготовку инокулята необходимо повторить [42].
Для показателей, требующих определения
количества внесенных микроорганизмов, рассчитывают посевную дозу.
Посевная доза - объем конкретного разведения, содержащий
необходимое для посева количество жизнеспособных клеток тестового
микроорганизма. Расчет дозы выполняют, основываясь на ранее определенных
концентрациях тестового микроорганизма в 6 и 7 разведениях, исходя из
требований, что посев на одну чашку не должен превышать 50 - 100 микробных
клеток. При правильно выполненном разведении посевная доза составляет 50 - 100
мкл суспензии из 6 разведения [42].
После расчета посевной дозы определяют
необходимое количество повторов посевов (не менее 5) исходя из расчета, что
суммарное количество колоний на всех чашках на одной среде должно составлять не
менее 200 КОЕ/мл.
Приготовленные суспензии можно использовать,
если они были охлаждены сразу же после приготовления и произведения контрольных
высевов и не хранились более 24 часов. Перед исследованием инокулят следует
тщательно перемешивать, чтобы добиться однородности суспензии микроорганизмов.
2.2.3 Определение роста
микроорганизмов при различных температурах
Для наблюдения роста микроорганизмов
использовали универсальную агаризованную среду МПА. Это связано с тем, что
культивирование с целью изучения роста микроорганизмов на твердой питательной
среде позволяет характер роста и произвести визуальную оценку.
Посев испытуемых культур производился на чашки
Петри со стерильной питательной средой методом штриха. Чашку Петри разделили на
4 зоны, в одной зоне сеяли одну культуру, так чтобы в результате в одной чашке
вырастали 4 культуры. Далее инокулированные чашки культивировали при
необходимом температурном режиме. Для культивирования при -5°С, чашки Петри
помещали в холодильник предварительно измерив температуру лабораторным
градусником, для культивирования при +20°С чашки помещали в термостат.
Длительность культивирования 24 часа. Для сравнения роста микроорганизмов при
-5°С и +20°С, испытуемые культуры также культивировались при 37°С (Рисунок 2).



Рисунок 2. Изучение роста микроорганизмов при
температуре +5° С и +20° С
Для изучение роста микроорганизмов при 60° С
агаризованную среду следует заменить на жидкую питательную среду МПБ.
Температура плавления МПА составляет 50° С, в связи с этим возникают трудности
с визуальной оценкой интенсивности роста. Для оценки интенсивности роста
используем подсчет общего микробного числа до и после культивирования.
Первым этапом изучения роста микроорганизмов
является активизация культур. Культуры активизировали путем культивирования
испытуемых микроорганизмов в 5 мл МПБ при +30° С 24 часа. Далее из этой
суспензии 1 мл инокулировали в пробирку с 9 мл исходной среды после чего
культивировали при +60° С. Для определения количества клеток внесенных в среду
методом последовательных разведений (методом Коха) со второго и третьего
разведения производился посев на чашки Петри. Далее чашки культивировали 24
часа при +30° С, после чего подсчитывали выросшие колонии и вычисляли КОЕ/мл.
Также ОМЧ определяли после культивирования при +60° С, однако в этом случае на
чашки Петри высевали из нулевого, первого и второго разведения, которые также
культивировали 24 часа при +30° С, после чего подсчитывали выросшие колонии и
вычисляли КОЕ/мл (Рисунок 3).

Рисунок 3. Изучение роста микроорганизмов при
температуре +60° С
2.2.4 Определение
количества микробных клеток высевом на плотные питательные среды (Метод Коха)
Метод широко применяют для определения
численности жизнеспособных клеток в различных естественных субстратах и в
лабораторных культурах. В его основе лежит принцип Коха, согласно которому
каждая колония является потомством одной клетки. Это позволяет на основании
числа колоний, выросших после посева на плотную питательную среду определенного
объема исследуемой суспензии, судить об исходном содержании в ней клеток
микроорганизмов. Результаты количественного определения микроорганизмов,
проведенного по методу Коха, часто выражают не в числе клеток, а в условных,
так называемых колониеобразующих единицах.
Определение числа микроорганизмов этим методом
включает три этапа: приготовление разведений, посев на плотную среду в чашки
Петри и подсчет выросших колоний.
Разведения готовят в стерильной водопроводной
воде. Для приготовления разведений стерильную водопроводную воду разливают по 9
мл в сухие стерильные пробирки. Затем 1 мл исследуемой суспензии стерильной
пипеткой переносят в пробирку с 9мл стерильной воды - это первое разведение.
Для приготовления каждого разведения следует обязательно использовать новую
пипетку. Пренебрежение этим правилом приводит к получению ошибочного результата
вследствие высокой способности клеток микроорганизмов к сорбции на поверхности
стекла.
Полученное разведение тщательно перемешивают
новой стерильной пипеткой, несколько раз вбирая в пипетку и выпуская из нее
полученную суспензию клеток. Затем той же пипеткой отбирают 1 мл суспензии и
переносят во вторую пробирку, получая второе разведение. Таким же образом
готовят последующие разведения. Степень разведения зависит от плотности
исследуемой популяции микроорганизмов.
Высевать суспензию поверхностным способом. Перед
посевом поверхностным способом разливают агаризованную питательную среду в ряд
стерильных чашек Петри по 15-20 мл в каждую. Чашки оставляют на горизонтальной
поверхности, пока среда не застынет [43].
В чашку Петри с подсушенной средой вносят точно
измеренный объем (0,1 мл) соответствующего разведения и распределяют его
стеклянным шпателем по поверхности среды. После посева чашки Петри помещают в
термостат крышками вниз.
Сроки учета зависят от состава питательной
среды. Количество колонии, выросших на плотной среде подсчитывают и вычисляют
по формуле 1:
M=а*10n/V, (1)
где М - количество клеток в 1 мл; а - среднее
число колоний, выросших после посева из данного разведения; V - объем
суспензии, взятый для посева, мл; 10n - коэффициент разведения.
3. Результаты
исследования и их обсуждение
.1 Выделение и изучение
аборигенных углеводородокисляющих микроорганизмов
Участие микроорганизмов в деградации и
трансформации различных ксенобиотиков общепризнано. Углеводороды, в зависимости
от степени сложности их молекул, разлагаются микроорганизмами различным
образом. Установлено, что лучше всего бактериями усваиваются н-парафины, слабее
- циклические и, в меньшей степени, полициклические ароматические углеводороды.
Ассимиляция микроорганизмами ароматических углеводородов характерна лишь для
отдельных штаммов некоторых видов микроорганизмов и является штаммовым
свойством, возникающим в результате длительной адаптации, в связи с чем, при
разработке биотехнологий для очистки различных экосистем техногенного
происхождения первоначальной задачей является выделение и отбор высокоактивных
культур микроорганизмов - деструкторов токсичных органических соединений.
В наших исследованиях для выделения и отбора
активных культур микроорганизмов-деструкторов нефти использовались 2 метода:
метод выделения из накопительных культур с
нефтью;
поиск активных штаммов - деструкторов
органических соединений среди культур, хранящихся в музее кафедры биотехнологии
КазНУ им. аль-Фараби.
Характеристика изучаемых 6 проб нефтешлама
(БВН-1, БВН-3, БШС-2, БШН-4, ЗГ-4, БШН(ц)-4) представлена в таблице 1. Для
получения накопительных культур нефтеокисляющих микроорганизмов из
вышеперечисленных проб полигона-накопителя отходов нефтедобычи, в качестве
элективного фактора и единственного источника углерода использовалась нефть с
концентрацией 80% по объему минеральной жидкой среды Е8. Следует отметить, что
элективные условия далеко не всегда оптимальны для роста выделяемых
микроорганизмов, однако они лучше переносятся ими, чем сопутствующими формами.
Таблица 1.
Названия и описание проб образцов, взятых для
анализа
|
№
|
Название
проб
|
Сокращенное
название
|
Описание
|
|
1
|
2
|
3
|
4
|
|
1
|
Буровые
сточные воды с нефтью (карта 1)
|
БВН-1
|
несмешиваемая
двухфазная водно-маслянистая жидкость, темно-коричневого цвета
|
|
2
|
Буровые
сточные воды (карта 3)
|
БВН-3
|
Гомогенная
жидкость темно-коричневого цвета
|
|
3
|
Буровой
шлам «старый» (карта 2)
|
БШС-2
|
Твердая
фракция грунта, со слабым запахом нефти, отстоявший в течение года на карте №
2
|
|
4
|
Буровой
шлам «новый» (карта 4)
|
БШН-4
|
Твердая
фракция грунта, с резким запахом нефти, собираемый в течение 1-3 месяцев на
карте №4
|
На рисунке 4 представлены фотографии получения
накопительных нефтеокисляющих культур из проб БВН-1 и БШН-4 полигона накопителя
отходов нефтедобычи.
Как видно из рисунка 4, в накопительных суточных
культурах нет видимых изменений ни в цвете среды, ни в консистенции нефти,
тогда как, на 6-7 сутки во всех пробах наблюдаются визуальные признаки развития
накопительных культур, такие как изменение консистенции, цвета среды
культивирования, образование эмульсии капель нефти, накопление хлопьевидного
осадка. Однако, накопительные культуры БВН-1, ЗГ-4 и БШС-2 характеризуются
более обильным образованием осадка, что косвенно свидетельствует о более
интенсивном процессе биодеградации углеводородов нефти микроорганизмами в
условиях отсутствия других источника углерода. Таким образом, из твердых и
жидких фракций нефтешлама полигона-накопителя месторождения «Жанажол» были
получены 5 накопительных нефтеокисляющих культур, обозначенных нами как БВН-1,
БВН-3, БШС-2, БШН-4, ЗГ-4, БШН(ц)-4.

Суточные культуры

Шестисуточные
культуры
Рисунок 4. Получение накопительных культур
нефтеокисляющих микроорганизмов из проб БВН-1 и БШН-4
Далее, накопительная нефтеокисляющая культура
микроорганизмов пересевалась на плотную среду МПА для получения изолированных
колоний углеводородокисляющих микроорганизмов. Затем, доминирующие колонии
микроорганизмов отсевались для получения бактериологически чистой культуры
угловодородокисляющих микроорганизмов.
В таблице 2 представлены результаты выделения
бактериологически чистых культур нефтеокисляющих микроорганизмов из
накопительных культур, полученных из различных проб полигона-накопителя ТОО
ХимпромсервисАктобе» месторождения «Жанажол».
Таблица 2.
Культуры микроорганизмов, выделенные из
различных проб полигона-накопителя ТОО «ХимпромсервисАктобе» месторождения
«Жанажол»
|
№
|
Образцы
проб
|
Накопительная
культура
|
Всего
культур
|
Число
культур с одной пробы
|
Сокращенное
название культур микроорганизмов
|
|
1
|
Буровые
сточные воды с нефтью (карта 1)
|
БВН-1
|
1.
|
1
|
БВН-1
|
|
2
|
Буровой
шлам старый (карта 2)
|
БШС-2
|
2.
|
1
|
БШС-1
|
|
|
|
3.
|
2
|
БШС-2
|
|
3
|
Буровой
шлам новый (карта 4)
|
БШН-4
|
4.
|
1
|
БШН-1
|
|
|
|
5.
|
2
|
БШН-2
|
|
|
|
6.
|
3
|
БШН-3
|
|
|
|
7.
|
4
|
БШН-4
|
|
4
|
Буровой
шлам с цементом новый (карта 4)
|
БШН(ц)-4
|
8.
|
1
|
БШН(ц)
|
|
5
|
Замазученный
грунт (карта 4)
|
ЗГ-4
|
9.
|
1
|
ЗГ-1
|
|
|
|
10.
|
2
|
ЗГ-2
|
Идентификацию культур проводили общепринятыми
методами на основании изучения морфологических, культуральных и
физиолого-биохимических признаков. Форму, величину, подвижность, наличие или
отсутствие спор, окрашивание по Грамму изучали с помощью лабораторного
микроскопа «Mоtiс
BА 300» по
общепринятым в лабораторной практике методикам. Морфологию и структуру колоний
определяли при росте на МПА. Для идентификации бактерий использовали
определитель Берги [44].
Результаты изучения морфолого-культуральных и
физиологических признаков бактерий БШС-1, БШС-2, БШН-1, БШН-2, БШН-3, БШН-4,
ЗГ-1, ЗГ-2, БШН (ц) и БВН-1 представлены в таблицах 3, 4, 5.
Таблица 3.
Макро- и микроморфологическая характеристика
культур аборигенных культур микроорганизмов
|
№
|
Культура
|
Описание
колоний
|
Морфология
клеток, х1300
|
Размеры
клеток, мкм
|
|
1.
|
БШС-1
|
круглые
с ровными краями, плоские, гладкие, желто-оранжевые, непрозрачные, блестящие
колонии, диаметр 1-3мм
|
Мелкие
палочки, расположены поодиночке
|
0,5-1,5
|
|
2.
|
БШС-2
|
круглые
с ровными краями, плоские, молочные, полупрозрачные, блестящие, диаметр 1-3
мм
|
Мелкие
палочки, расположены поодиночке
|
0,7-1,6
|
|
3.
|
БШН-1
|
круглые
с ровными краями, плоские, морщнистые, молочные, непрозрачные, матовые,
диаметр 2-5мм
|
Крупные
палочки, расположены поодиночке
|
1,2-3,6
|
|
4.
|
БШН-2
|
круглые
с ровными краями, плоские, морщнистые, молочные, непрозрачные, матовые,
диаметр 1-3 мм
|
Мелкие
палочки, расположены поодиночке
|
0,5-1,7
|
|
5.
|
БШН-3
|
круглые
с ровными краями, выпуклые, складчато-морщинистые, белые, полупрозрачные,
блестящие, диаметр 2-6мм
|
Крупные
одиночные и соединенные попарно палочки
|
1,6-4
|
|
6.
|
БШН-4
|
круглые
с ровными краями, плоские, гладкие, белые, полупрозрачные, блестящие, диаметр
2-5мм
|
Крупные
палочки, расположены поодиночке и попарно
|
1,5-3,5
|
|
7.
|
ЗГ-1
|
круглые
с ровными краями, выпуклые, гладкие, молочные, прозрачные, блестящие, диаметр
1-2 мм
|
Мелкие
палочки, расположены поодиночке
|
0,6-1,6
|
|
8.
|
ЗГ-2
|
круглые
с ровными краями, выпуклые, гладкие, желтые, прозрачные, блестящие, диаметр
1-2 мм
|
Мелкие
палочки, расположены поодиночке
|
0,6-1,8
|
|
9.
|
БШЦ-(ц)
|
круглые
с ровными краями, выпуклые, шероховатые, молочные, непрозрачные, блестящие,
диаметр 1-2 мм
|
Мелкие
палочки, расположены поодиночке
|
0,5-1,5
|
|
10.
|
БВН-1
|
круглые
с ровными краями, плоские, шероховатые, молочные, прозрачные, блестящие,
диаметр 1-2 мм
|
Мелкие
палочки, расположены поодиночке
|
0,6-1,6
|
В таблице 3 дано описание морфологий колоний и
клеток, а также размеров клеток, выделенных нами культур.
Согласно результатам, представленным в таблице
4, видно что, клетки всех культур являются денитрифицирующими подвижными
палочками, обладающими каталазной активностью, а клетки культур БШН-1, БШН-3,
БШН-4 относятся к спорообразующим, грамотрицательным моно- и диплобактериям.
Таблица 4.
Основные дифференциально-диагностические
признаки выделенных бактерий
|
№
п/п
|
Культура
|
Окраска
по Граму
|
Подвижность
|
Споры
|
Гидролиз
желатины
|
Наличие
каталазы
|
Наличие
оксидазы
|
Денитрификация
|
|
1
|
БШС-1
|
-
|
+
|
-
|
-
|
+
|
+
|
+
|
|
2
|
БШС-2
|
-
|
+
|
-
|
+
|
+
|
+
|
+
|
|
3
|
БШН-1
|
+
|
+
|
+
|
+
|
+
|
+
|
+
|
|
4
|
БШН-2
|
-
|
+
|
-
|
+
|
+
|
+
|
+
|
|
5
|
БШН-3
|
+
|
+
|
+
|
+
|
+
|
+
|
+
|
|
6
|
БШН-4
|
+
|
+
|
+
|
+
|
+
|
+
|
+
|
|
7
|
ЗГ-1
|
+
|
-
|
+
|
+
|
+
|
+
|
|
8
|
ЗГ-2
|
-
|
+
|
-
|
+
|
+
|
-
|
+
|
|
9
|
БШН-(ц)
|
-
|
+
|
-
|
-
|
+
|
+
|
+
|
|
10
|
БВН1
|
-
|
+
|
-
|
+
|
+
|
+
|
+
|
Усвоение углеводов определяли по потреблению
углеводов в течение 2-х недель на средах, содержавших соответствующие растворы
сахаров (в концентрации 1%) с добавлением индикатора бромтимолблау (0,016 %
спиртовой раствор). Полученные данные представлены в таблице 5. Как видно, все
культуры сбраживают углеводы и спирты, следует отметить, что все культуры кроме
ЗГ-2, которая при сбраживании маннита образует щелочь и газ, сбраживают
исследуемые источники углерода до кислоты и газа, тогда как при ферментации
глицерина все культуры образуют только кислоты.
Таблица 5.
Усвоение углеводов культурами
выделенных бактерий
|
Углеводы
|
Культуры
|
|
БШС-1
|
БШС-2
|
БШН-1
|
БШН-2
|
БШН-3
|
БШН-4
|
ЗГ-1
|
ЗГ-2
|
БШН-ц
|
БШН
|
БВН-1
|
|
1
|
2
|
3
|
4
|
5
|
6
|
7
|
8
|
9
|
10
|
11
|
12
|
|
Углеводы
|
|
Глюкоза
|
к,
г
|
к
|
к,
г
|
к,
г
|
к,
г
|
к,
г
|
к,
г
|
к
|
к,
г
|
к
|
к,
г
|
|
Ксилоза
|
к,
г
|
к,
г
|
к,
г
|
к,
г
|
к
|
к,
г
|
к,
г
|
к
|
к,
г
|
к,
г
|
к,
г
|
|
Сахароза
|
к,
г
|
к
|
к,
г
|
к,
г
|
к,
г
|
к
|
к,
г
|
к
|
к,
г
|
к,
г
|
к
|
|
Галактоза
|
к
|
к,
г
|
к
|
к,
г
|
к,
г
|
к,
г
|
к,
г
|
к
|
к,
г
|
к,
г
|
к,г
|
|
Мальтоза
|
к,
г
|
к,
г
|
к,
г
|
к
|
к,
г
|
к,
г
|
к,
г
|
к,
г
|
к,
г
|
К
|
к,г
|
|
Лактоза
|
к
|
к,
г
|
к,
г
|
к,
г
|
к
|
к
|
к,
г
|
к,
г
|
к,
г
|
К
|
к,
г
|
|
Арабиноза
|
к
|
к
|
к,
г
|
к,
г
|
к,
г
|
к,
г
|
к,
г
|
к,
г
|
к,
г
|
к,
г
|
к
|
|
Фруктоза
|
к,
г
|
к,
г
|
к,
г
|
к,
г
|
к
|
к
|
к
|
к,
г
|
к,
г
|
К
|
к,
г
|
|
Спирты
|
|
глицерин
|
к
|
к
|
к
|
к
|
к
|
к
|
к
|
к
|
к
|
к
|
к
|
|
маннит
|
к,
г
|
к,
г
|
к,
г
|
к,
г
|
к,
г
|
к,
г
|
к,
г
|
щ,
г
|
к,
г
|
к,
г
|
к,г
|
|
Примечание
- к - кислота, г - газ, щ - щелочь, б/и - без изменений
|
|
|
|
|
|
|
|
|
|
|
|
|
|
На рисунке 5 представлены микрофотографии клеток
культур БШН-3, БШН-1, БШН-4, БВН-1. Как видно, культура БШН-3 и БШН-4
представлена крупными одиночными и соединенными попарно палочками,
БШН-1 и БВН-1 - одиночные палочки.

БШН-3

БШН-1

БШН-4

БВН-1
Рисунок 5. Морфология клеток культур, выделенных
из буровых сточных вод и шлама, х1000
На основании результатов
морфолого-культуральных и физиолого-биохимических признаков, выделенные культуры
бактерий
идентифицированы нами как представители родов Рsеudоmоnаs
и Bасillus,
а именно: культуры БШС-1, БШС-2, БШН-2, ЗГ-1,
ЗГ-2, БШН -(ц), БВН-1
отнесены к роду Рsеudоmоnаs,
культуры БШН-1, БШН-3, БШН-4 отнесены к роду Bасillus.
3.2 Изучение
нефтеокисляющей активности микроорганизмов при различных температурных режимах
Эффективность применения биопрепаратов в разных
почвенно-климатических зонах, для удаления определенных по химическому составу
загрязнений обусловлена физиолого-биохимическими свойствами штаммов -
биодеструкторов (термотолерантность, осмофильность, оптимальные для роста
значения рН и др.). Одним из приоритетных решений для Западного Казахстана
является использование биологических методов очистки от нефтезагрязнений с
применением микроорганизмов-деструкторов способных функционировать при
экстремальных температурах.
В наших исследованиях для изучения интенсивности
роста 10 аборигенных культур микроорганизмов: Рs.
ssр. БШС-1,Рs.
ssр. БШС-2, Bас.
ssр. БШН-1, Рs.
ssр. БШН-2, Bас.
ssр. БШН-3, Bас.
ssр. БШН-4, Рs.
ssр. ЗГ-1, Рs.
ssр. ЗГ-2, Рs.
ssр. БШН-(ц), Рs.
ssр. БВН, а
также коллекционной Рs.
аеruginоsа
Н14 проводили культивирование при температурах +5°С, +20°С +60°С на
универсальной среде.
Результаты изучения интенсивности роста 10
углеводородокисляющих аборигенных культур микроорганизмов и Рs.
аеruginоsа
Н14 при различных температурах представлены в таблице 6. В качестве контроля
использовали вариант роста микроорганизмов при +37°С.
Таблица 6.
Рост микроорганизмов при различных температурах
в течении 24 часов
|
№
|
Культуры
микроорганизмов
|
Интенсивность
роста
|
|
|
+37°С
|
+5°С
|
+20°С
|
|
1.
|
Рs. ssр.
БШС-1
|
++
|
-
|
++
|
|
2.
|
Рs. ssр. БШС-2
|
++
|
-
|
++
|
|
3.
|
Bас.
ssр. БШН-1
|
+++
|
-
|
++
|
|
4.
|
Рs. ssр. БШН-2
|
+++
|
-
|
++
|
|
5.
|
Bас. ssр.
БШН-3
|
+++
|
-
|
+++
|
|
6.
|
Bас.
ssр. БШН-4
|
+++
|
-
|
++
|
|
7.
|
Рs. ssр. ЗГ-1
|
++
|
+
|
++
|
|
8.
|
Рs. ssр. ЗГ-2
|
+++
|
-
|
+++
|
|
9.
|
Рs. ssр. БШН-(ц)
|
+++
|
+
|
++
|
|
10.
|
Рs. ssр.
БВН
|
+++
|
+
|
++
|
|
11.
|
Рs. аеrоgеnоsа
Н14
|
+++
|
-
|
++
|
|
Примечание:"-"-
роста нет, "+"-слабый рост, "++"- умеренные рост,
"+++"- обильный рост.
|
Как видно, при +5°С все культуры не способны к
росту, кроме культур Рs.
ssр. ЗГ-1, Рs.
ssр. БШН-(ц), Рs.
ssр. БВН для которых
наблюдается слабый рост, тогда как при +20°С для 2 культур наблюдается обильный
рост: Bас. ssр.
БШН-3, Рs. ssр.
ЗГ-2, а для остальных 9 культур - умеренный рост клеток. В контроле у всех
культур наблюдается обильный рост, кроме 2 культур Рs.
ssр. ЗГ-1 и Рs.
ssр. БШС-2 которые
показали умеренный рост.
На рисунке 6, 7 представлены фотографии роста
углеводородокисляющих культур при температуре +5°С и +20°С в течении 24 часов.


Культуры ЗГ-1, ЗГ-2, БШН-(ц) Культуры БШС-1,
БШС-2, БШН-3, БШН-4
Рисунок 6. Рост углеводородокисляющих культур
микроорганизмов на МПА при +5°С

Культуры БШС-1, БШС-2, ЗГ-1, Зг-2 Культуры
БШН-1, БШН-2, БШН-3, БШН-4
Рисунок 7. Оценка интенсивности роста
исследуемых культур микроорганизмов при температуре +20°С
Как видно на рисунке 6, рост культур Рsеudоmоnаs
ssр. ЗГ-1 и Рsеudоmоnаs
ssр. БШН-(ц) слабый,
а для культур Рsеudоmоnаs
ssр. БШС-1, Рsеudоmоnаs
ssр. БШС-2, Bасillus
ssр. БШН-3, Bасillus
ssр. БШН-4 не
наблюдается, а на рисунке 7 видно, что у культур Bасillus
ssр. БШН-3, Рs.
ssр. ЗГ-2 наблюдается
обильный рост, у остальных культур Рs.
ssр. БШС-1, Рs.
ssр. БШС-2, Bас.
ssр. БШН-1, Рs.
ssр. БШН-2, Bас.
ssр. БШН-4, Рs.
ssр. ЗГ-1 наблюдался
умеренный рост.
Резко-континентальный климат Западного
Казахстана предполагает жаркое лето, с нагреванием поверхности почвы до +65°С,
в связи с чем, было проведено изучение роста углеводородокисляющих культур при
+60°С на жидкой среде МПБ.
В таблице 7 представлены результаты изменения
ОМЧ при культивировании при +60°С.
Таблица 7.
Изменение ОМЧ углеводородокисляющих культур
микроорганизмов при культивировании при +60°С
|
№
|
Название
культур
|
Исходная
среда с инокулятом, КОЕ/мл, 105
|
После
24-ч. культивирования КОЕ/мл,105
|
|
1
|
Рs. ssр.
БШС-1
|
96
|
5,92
|
|
2
|
Рs. ssр. БШС-2
|
139
|
1,92
|
|
3
|
Bас.
ssр. БШН-1
|
289
|
6,72
|
|
4
|
Рs. ssр. БШН-2
|
23,4
|
13,4
|
|
5
|
Bас. ssр.
БШН-3
|
122
|
6,24
|
|
6
|
Bас.
ssр. БШН-4
|
41,5
|
9,1
|
|
7
|
Рs. ssр. ЗГ-1
|
359
|
0,54
|
|
8
|
Рs. ssр. ЗГ-2
|
413
|
2,2
|
|
9
|
Рs. ssр. БШН-(ц)
|
36,1
|
0,08
|
|
10
|
Рs. ssр.
БВН
|
151
|
10,6
|
|
11
|
Рs. аеruginоsа
Н14
|
153
|
0,01
|
Таким образом, результаты ОМЧ до культивирования
при +60°С необходимы для определения количества клеток внесенных в суспензию. В
результате у нас получилось, что самое большое количество клеток оказалось у 3
культур: Рs. ssр.
ЗГ-2, Рs. ssр.
ЗГ-1, Bас. ssр.
БШН-1, меньше всего клеток оказалось у 3 культур: Рs.
ssр. БШН-(ц), Bас.
ssр. БШН-4, Рs.
ssр. БШС-1.
После культивирования углеводородокисляющих
микроорганизмов при +60°С высокие значения наблюдались у 3 культур: Рs.
ssр. БШН-2, Рs.
ssр. БВН, Bас.
ssр. БШН-4,
наименьшее значение КОЕ/мл было у 4 культур: Рs.
ssр. БВН, Рs.
аеruginоsа
Н14, Рs. ssр.
ЗГ-1, Рs. ssр.
БШС-2.
Для изучения влияния различных температур на
нефтеокисляющую активность микроорганизмов-деструкторов в минеральной среде с
содержанием нефти 10%, где нефть использовалась в качестве единственного
источника углерода и энергии. В качестве контроля использовали вариант
минеральной средой Е8 с содержанием 10% нефти без микроорганизмов. В течении 12
суток через каждые 3 дня производился посев на чашки с твердой питательной
средой и подсчитывалось общее число выросших колоний с различных разведений.
Количественные результаты роста монокультур и
ассоциаций микроорганизмов-нефтедеструкторов на среде с нефтью (10%)
представлены в таблице 8, 9, 10 и в виде графика на рисунке 8,
длительность культивирования составляла 12 суток.
Наибольшее количество клеток наблюдали на 6
сутки культивирования, для все культур, а на 9 сутки культивирования
углводородокисляющих микроорганизмов количество выросших колоний стабильно
стало уменьшаться, что свидетельствовало о гибели клеток в результате
недостатка питательных веществ и накопления продуктов метаболизма.
Таблица 8.
Количество клеток УОМ при культивировании при
+5°С
|
Время
культивирования, сут
|
Наименования
культур/ОМЧ (КОЕ/мл), 107
|
|
БШС-1
|
БШС-2
|
БШН-1
|
БШН-2
|
БШН-3
|
БШН-4
|
ЗГ-1
|
ЗГ-2
|
БВН
|
БШН-(ц)
|
Рs. аеr.
Н14
|
|
0
|
10±0,04
|
16±0,01
|
22±0,03
|
12±0,02
|
16±0,04
|
20±0,02
|
21±0,03
|
15±0,05
|
24±0,04
|
14±0,01
|
|
3
|
15±0,01
|
17±0,02
|
24±0,04
|
13±0,03
|
18±0,03
|
13±0,03
|
21
|
25±0,05
|
18±0,01
|
26±0,05
|
16±0,03
|
|
6
|
23±0,03
|
22±0,05
|
26±0,01
|
15±0,01
|
24±0,02
|
15±0,05
|
24±0,02
|
30±0,05
|
21±0,03
|
27±0,03
|
26±0,01
|
|
9
|
24±0,04
|
24±0,04
|
24±0,01
|
16±0,04
|
21±0,01
|
12±0,04
|
23±0,03
|
31±0,04
|
37±0,02
|
24±0,02
|
28±0,04
|
|
12
|
21±0,04
|
21±0,03
|
21±0,04
|
10±0,03
|
19±0,02
|
6±0,01
|
19±0,05
|
30±0,05
|
28±0,01
|
20±0,02
|
21±0,03
|
Таблица 9.
Количество клеток УОМ при культивировании при
+20°С
|
Время
культивирования, сут.
|
Наименования
культур/ОМЧ (КОЕ/мл), 107
|
|
БШС-1
|
БШС-2
|
БШН-1
|
БШН-2
|
БШН-3
|
БШН-4
|
ЗГ-1
|
ЗГ-2
|
БВН
|
БШН-(ц)
|
Рs.
аеr. Н14
|
|
0
|
19±0,04
|
10±0,01
|
16±0,02
|
18±0,02
|
12±0,05
|
11±0,04
|
25±0,02
|
22±0,05
|
19±0,01
|
14±0,02
|
23±0,01
|
|
3
|
98±0,02
|
52±0,02
|
35±0,04
|
33±0,04
|
15,7±0,01
|
24,2±0,05
|
174±0,05
|
110±0,01
|
66±0,02
|
68±0,05
|
389±0,01
|
|
6
|
616±0,04
|
236±0,05
|
112±0,02
|
150±0,05
|
330±0,02
|
120±0,05
|
510±0,04
|
986±0,05
|
256±0,05
|
215±0,02
|
860±0,04
|
|
9
|
493±0,01
|
152±0,04
|
90±0,02
|
493±0,02
|
210±0,05
|
300±0,04
|
175±0,02
|
810±0,04
|
147±0,02
|
165±0,01
|
110±0,02
|
|
12
|
154±0,05
|
32±0,02
|
61±0,02
|
90±0,04
|
66±0,01
|
85±0,05
|
45±0,01
|
158±0,02
|
95±0,05
|
103±0,04
|
98±0,01
|
Таблица 10.
Количество клеток УОМ при культивировании при
+60°С
|
Время
культивирования, сут.
|
Наименования
культур/ОМЧ (КОЕ/мл), 107
|
|
БШС-1
|
БШС-2
|
БШН-1
|
БШН-2
|
БШН-3
|
БШН-4
|
ЗГ-1
|
ЗГ-2
|
БВН
|
БШН-(ц)
|
Рs.
аеr. Н14
|
|
0
|
19±0,04
|
10±0,02
|
16±0,01
|
18±0,02
|
12±0,02
|
11±0,04
|
25±0,05
|
22±0,01
|
19±0,02
|
14±0,02
|
23±0,05
|
|
3
|
10±0,01
|
9±0,05
|
7±0,04
|
10±0,05
|
9±0,04
|
6±0,01
|
17±0,02
|
14±0,04
|
7±0,05
|
9±0,04
|
11±0,01
|
|
6
|
5±0,05
|
5±0,01
|
4±0,02
|
3±0,05
|
2±0,01
|
4±0,05
|
8±0,05
|
9±0,02
|
1±0,04
|
4±0,02
|
6±0,05
|
|
9
|
1±0,04
|
2±0,05
|
0,12±0,02
|
0,74±0,02
|
1±0,02
|
0,02±0,05
|
0.15±0,05
|
0.24±0,02
|
0.01±0,05
|
2±0,01
|
0.14±0,02
|
|
12
|
0,06±0,05
|
0,52±0,04
|
0,03±0,02
|
0,02±0,04
|
0,12±0,05
|
0,004±0,05
|
0.01±0,01
|
0.012±0,02
|
0.006±0,04
|
0.004±0,05
|
0.071±0,04
|
Основываясь на результатах, представленных на
таблице 8 и 10, все углеводородокисляющие культуры не способны к нефтеокислению
при +5°С, а при +60°С наблюдается уменьшение количества клеток.

Рисунок 8. График динамики роста
углеводородокисляющих культур при +20°С
Как видно, на рисунке 8 представлен
график изменения роста УОМ при температуре +20°С. В контрольном варианте
изменения не наблюдалось, что говорит об исключении возможности роста
посторонней микрофлоры.
Высокую нефтеокислительную
активность наблюдали у 3 культур: Рs. ssр. БШС-1, Рs. ssр. ЗГ-2 и Рs. аеruginоsа Н14, а
низкую нефтеокисляющую активность наблюдали у 4 культур: Bас. ssр. БШН-1, Рs. ssр. БШН-(ц),
Рs. ssр. БШС-2, Рs. ssр. БВН.
Как видно, пик нефтедеструктирующей
активности культур Рs. ssр. БШС-1, Рs. ssр. ЗГ-2 и Рs. аеruginоsа Н14
наблюдается на 6 день культивирования, где максимальное число клеток достигает
616*107 КОЕ/мл у культуры Рs. ssр. БШС-1,
986*107КОЕ/мл у Рs. ssр. ЗГ-2,
860*107КОЕ/мл у Рs. аеruginоsа Н14.
Увеличение числа клеток косвенно свидетельствует об увеличении нефтеокисляющей
активности.
ЗАКЛЮЧЕНИЕ
В результате исследований,
сделаны следующие выводы:
1. Из 6 проб нефтеотходов месторождения
Жанажол (Актюбинская обл.) выделены 10 культур бактерий, способных расти на
среде с высокой концентрацией нефти (80%), используя ее в качестве
единственного источника углерода и энергии.
2. Выделенные аборигенные культуры идентифицированы
нами как представители родов Рsеudоmоnаs
и Bасillus,
3. Установлено, что на среде с 10% нефти
при +5°С и +60°С роста углеводородокисляющих микроорганизмов не наблюдается,
при +20°С - обильный рост характерен для следующих микроорганизмов Рs.
ssр. ЗГ-2, Рs.
ssр. БШС-1 и Рs.
аеruginоsа
Н14.
СПИСОК ИСПОЛЬЗОВАННОЙ
ЛИТЕРАТУРЫ
1 Информационно-аналитический
отчет по контрольной и правоприменительной деятельности Актюбинской
экологической инспекции за 2010 год / Министерство охраны окружающей среды
Республики Казахстан. Тобыл-Торгайский департамент экологии. - Актобе, 2010. -
200 с.
2 Kаiyrmаnоvа
G. K.,
Аbdiеvа
G. Zh.,
Аkimbеkоv
N. Sh.
Miсrоbiаl
Соmроsitiоns
оf Оil-Соntаminаtеd
Sоils
in Wеstеrn
Kаzаkhstаn.
Сеntrаl
Аsiа in
thе Glоbаl
Соmmunity Сhаllеngеs
аnd Орроrtunitiеs.
Kimер Intеrnаtiоnаl
Rеsеrсh
Соnfеrеnсе.
4-6 Арril 2013. Аlmаty, 2013. Р.
34
3 Абросимов
А. А. Экология переработки углеводородных систем / Под ред. М. Ю. Доломатова,
Э. Г. Теляшева. -М.: Химия, 2002.- 608 с.
Иванов
А. Ю., Гаврюшкин А. В. и др.. Устойчивость некоторых штаммов бактерий рода
Рsеudоmоnаs к повреждающему действию ионов тяжелых металлов.//Микробиология.,
Т.68,- №3, -1999. -С. 366-374.
Логинов
О. Н. Биотехнологические методы очистки окружающей среды от техногенных
загрязнений / О. Н. Логинов, Н. Н, Силищев, Т. Ф. Бойко, Н. Ф.
Галимзянова.-Уфа: Гос. изд. научно-тех. литературы «Реактив», 2000. - 100 с.
Государственный
доклад о состоянии и об охране окружающей среды Иркутской области в 2003 году.
- Иркутск: Изд-во «Облмашинформ», 2004.-296с.
7 Киреева
Н. А. Микробиологическая оценка почвы, загрязненной нефтяными углеводородами /
Н. А. Киреева // Баш. Хим. ж.-1995.-2, № 3-4.-С. 65-68.
8 Киреева
Н. А. Состояние комплекса актиномицетов нефтезагрязненных почв / Н. А. Киреева
// Вест. Баш. Ун-та.-1996.- № 1.-С. 42-45.
9 Киреева
Н. А. Фитотоксичность антропогенно-загрязненных почв / Н. А. Киреева, Г. Г.
Кузяхметов, А. М. Мифтахова, В. В. Водопьянов.-Уфа Гилем, 2003.
Колесниченко
А. В. Процессы биодеградации в нефтезагрязненных почвах / А. В. Колесниченко,
А. И. Марченко, Т. П. Побежимова, В. В. Зыкова.- Москва: «Промэкобезопасность»,
2004. - 194 с.
Киреева
Н. А. Биологическая активность нефтезагрязненных почв / Н. А. Киреева, В. В.
Водопьянов, А. М. Мифтахова. - Уфа Гилем, 2001.
Саксонов
М. А. Экологический мониторинг нефтегазовой отрасли / М. А. Саксонов, А. Д.
Абалаков, Л. В. Данько, О. А. Бархатова, А. Э. Балаян, Д. И. Стом //
Физико-химические и биологические методы. - Иркутск: Иркут. Ун-т, 2005.-114 с.
Сидорова
Е. В. Охрана почв на объектах газовой промышленности / Е. В. Сидорова, Г. С.
Акопова, Н. С. Немкова.- М.: ИРЦ Газпрома, 1994.- 50 с.
Реймерс
Н. Ф. Природопользование / Н. Ф. Реймерс // Словарь-справочник. - М.: Мысль,
1990.-637 с.
Логинов
О. Н. Биотехнологические методы очистки окружающей среды от техногенных
загрязнений / О. Н. Логинов, Н. Н, Силищев, Т. Ф. Бойко, Н. Ф. Галимзянова.-Уфа:
Гос. изд. научно-тех. литературы «Реактив», 2000. - 100 с.
Гриценко
А. И. Экология. Нефть и газ / А. И. Гриценко, Г. С. Акопов, В. М. Максимов. -
М.: Наука, 1997.-598 с.
Рrоvidеnti,
M.А., Lее,
H. аnd
Trеvоrs
J.С. Sеlесtеd
fасtоrs
limiting
thе miсrоbiаl
dеgrаdаtiоn
оf rесаlсitrаnt
соmроunds.
J.Industriаl
Miсrоbiоl. 1993.
Петрикевич
С. Б., Кобзев Е. Н., Шкидченко А. Н. Оценка углеводородокисляющей активности
микроорганизмов // Прикладная биохимия и микробиология. 2003. - Т. 39, -№ 1.
Исмаилов
Н. М. Микробиологическая и ферментативная активность нефтезагрязненных почв //
Восстановление нефтезагрязненных почвенных экосистем. - М.:, 1988.
Вельков
В. В. Биоремедиация: принциры, проблемы, подходы // Биотехнология. - 1995. -№
3-4.
Прутенская,
Е. А. Основы биотехнологии / Прутенская Е. А., Ожимкова Е. В..- Тверь: ТГТУ.
-2009.- 115с.
Сидоров
Д. Г. Полевой эксперимент по очистке почв от нефтяного загрязнения с
использованием углеводородокисляющих микроорганизмов / Д. Г. Сидоров, И. А.
Борзенков, Р. Р. Ибатулин, Е. И. Милехина, И. Т. Храмов, С. С. Беляев, М. В.
Иванов // Прикладная биохимия и микробиология.- 1997.- Т.33, №5.
23 Абдрахманов
Т. А. Роль нефтеокисляющих бактерий при очистке нефтезагрязнённых
лугово-аллювиальных почв //Научн. Журнал КубГАУ (электронный ресурс). -
Краснодар: Куб. ГАУ, 2006, №01(17), httр://www.еj.kubаgrо.ru/2006/01/14/
<http://www.ej.kubagro.ru/2006/01/14/>
24 Sоlаns
А. Dеgrаdаtiоn
оf аrоmаtiс
реtrоlеum
hydrосаrbоns
by рurе
miсrоbiаl
сulturеs
/ А. Sоlаns,
R. Раrеs
// Сhеmосhеrа.
- 1984. - Vоl.13,
№5. - Р. 593-601.
25 Сорбент
для очистки природных вод и почвы от нефтяных загрезнений "МОСКАТ"
(Патент RU 2143947).
26 Биопрепарат
"авалон" для очистки объектов окружающей среды от нефти и
нефтепродуктов, способ его получения (Патент RU 2181701).
27 Волченко
Т. И. Скрининг углеводородокисляющих бактерий - продуцентов
поверхностно-активных веществ биологической природы и их применение в опыте по
ремедиации нефтезагрязненной почвы и нефтешлама/ Н. Н. Волченко, Э. В. Карасёва
// Биотехнология.- 2008.-№6.-С.
28 Jаysrее
R. С., Subhаm Bаsu,
Рriyаnkа Р. Singh.
Isоlаtiоn оf biоsurfасtаnt рrоduсing bасtеriа frоm еnvirоnmеntаl sаmрlеs //
Рhаrmасоlоgyоnlinе.
- 2011.
- Р. 1427-1433.
29 Диаров
М. Д., Гилажов Е. Г., Димеева Л. А. Экология и нефтегазовый комплекс. - Алматы:
Ғалым, 2003. - Т. 2. - 340 с.
30 Сапаров
А. С., Фаизов К. Ш., Асанбаев И. К. Почвенно-экологическое состояние
Прикаспийского нефтегазового региона и пути их улучшения. - Алматы, 2006. - 148
с.
31 Жаров
О. А. Современные методы переработки нефтешламов // Экология производства. -
2004. - №5. - С. 43-51
32 Ермоленко
З. М., Чугунов В. А., Герасименко В. Н. Влияние некоторых факторов окружающей
среды на выживаемость внесенных бактерий, разрушающих нефтяные углеводороды //
Биотехнология. - 1997. - №5. - С. 18-26.
33 Пирог
Т. П., Антонюк С.И., Карпенко Е. В., Шевчук Т. А. Влияние условий
культивирования штамма Асinеtоbасtеr
саlсоасеtiсus
К-4 на синтез поверхностно-активных веществ // Прикладная биохимия и
микробиология. - 2009. - Т 45, №3, - С. 304-310.
34 Раlаshрriyа
Dаs,
Sоumеn
Mukhеrjее,
Rаmkrishnа
Sеn.
Substrаtе
dереndеnt
рrоduсtiоn
оf еxtrасеllulаr
biоsurfасtаnt
by а mаrinе
bасtеrium
// Biоrеsоurсе
Tесhnоlоgy.
- 2009. - Р. 1015-1019.
35 Vоlсhеnkо
N. N.,
Kаrаsеvа
Е. V. Srееning
оf hydrосаrbоn-оxidizing
biоsurfасtаnt-рrоduсing
bасtеriа
аnd thеir
аррliсаtiоn
tо thе
rеmеdiаtiоn
оf оil-роllutеd
sоil
аnd sludgе
// Biоtесhnоlоgy.-
2006.-№2.- Р.57-62
Реrsоn
А., Mоlin G. Сарасity fоr biоsurfасtаnt рrоduсtiоn оf еnvirоnmеntаl Рsеudоmоnаs
аnd Vibrоnасеае grоwing оn саrbоhydrаtеs. Аррl. Miсrоbiоl.
аnd Biоtесhnоl.
- 1987. - Vоl.26, N
5. - Р. 439-442.
Коронелли
Т. В. Принципы и методы интенсификации биологического разрушения углеводородов
в окружающей среде (обзор) / Т.В. Коронелли // Прикладная биохимия и
микробиология.-1996.- 32, № 6.- С.579-585.
38 Биоремедиация черноземной почвы,
загрязненной нефтью / В.Карасёва, Н. Гирич, И. Худокормов, Н. Алешина, С.
Карасёв// Биотехнология.- 2006.-№1.-С.27-34
39 Лысак В. В. Микробиология: учебное
пособие. - Минск: БГУ, 2007. - 426 с.
40 Кузнецова Е. А. Учебно-методическое
пособие «Микробиология» -250 с
41 Гусев М. В., Минеева Л. А. Микробиология:
Учебник для студ. биол. специальностей вузов.- 4-е изд., стер.- М.:
Издательский центр «Академия», 2003. - 464 с. нефть. 2002. - № 2. - С. 26-28.
42 Еvаns,
С.G.T.,
Hеrbеrt,
D., Tеmреst,
D.B.
//Mеthоds
in Miсrоbiоlоgy.
- 1970. - V. 2. - Р. 277-327.
43 Нетрусов А. И., Егорова М. А.,
Захарчук Л.М. Практикум по микробиологии: учеб.
пособие
для студ. высш.
учеб.заведений.
- М.: Изд. центр «Академия»,
2005. - 608 с.
44 Определитель
бактерии Берджи // Под
редакцией Дж. Хоулта, Н. Крига, П. Снита, Дж. Стейли и С. Уилльмса. Девятое
издание. в двух томах. -
Москва:
Мир,
2007.
-
Т.
1. - 512
с.